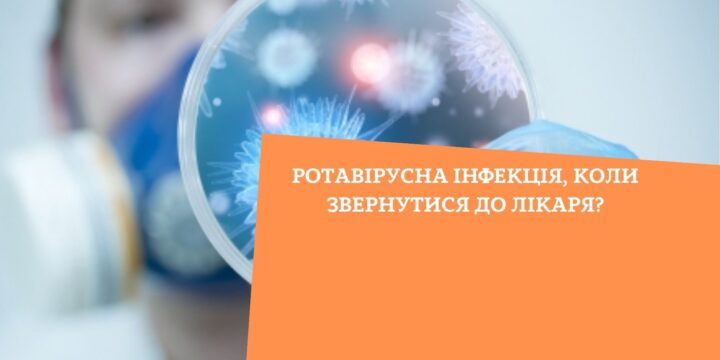
Ротавірусна інфекція, коли звернутися до лікаря?

Ротавірусна інфекція, коли звернутися до лікаря?
Ротавірусна інфекція — одна з форм гострої кишкової інфекції, збудником якої є ротавірус людини. Передається збудник під час контакту з поверхнями чи предметами, що могли бути забруднені фекаліями: іграшки, меблі, одяг, підлога, або під час вживання в їжу інфікованих продуктів харчування. (більше…)






